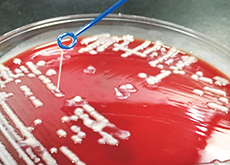

大学获研究影响基金拨款进行具影响力的研究
在研究资助局2018/19年度研究影响基金拨款当中,由理大带领的十个项目共获得六千五百万元资助。当中一半项目与健康有关,范畴涵盖药物开发、脊柱侧弯检测、近视控制及食物安全,足证理大科研的独特优势,为人类带来福祉。以下是四个例子:
应对抗生素的抗药性
陈声教授发现了三种化合物,它们可与较低剂量的粘菌素抗生素结合使用,以对付肠杆菌科和耐粘菌素的菌株,并减低毒性副作用。
|

无辐射三维检测脊柱侧弯 |

射频标签追踪提升食物安全 |

减慢近视加深的治疗法 |